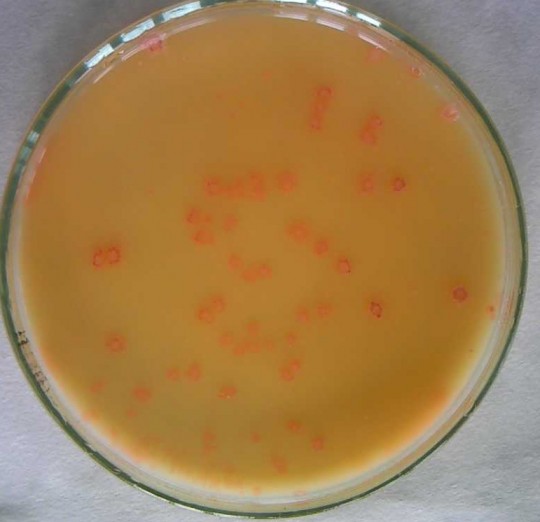
19. Jogurtová kultura na LS mediu
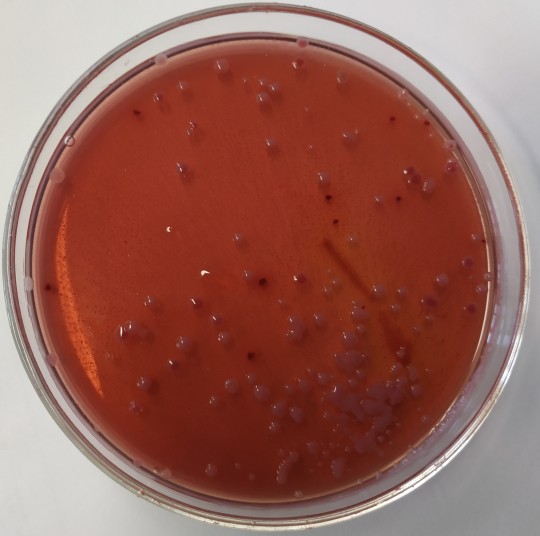
20. Koliformní bakterie na VČŽL.
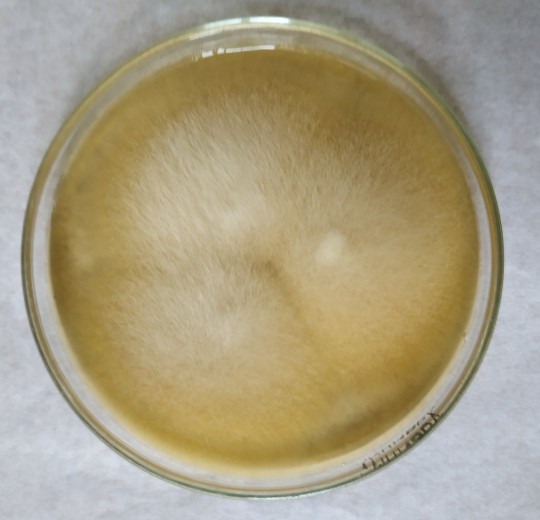
22. Geotrichum candidum

2.7
Mikroflóra kysaných mléčných výrobků
Definice
Kysaným nebo zakysaným mléčným výrobkem je mléčný výrobek získaný kysáním mléka, smetany, podmáslí, syrovátky nebo jejich směsi za použití mikroorganizmů, tepelně neošetřený po kysacím procesu. U jogurtu lze zvýšit obsah sušiny pouze přidáním mléčné bílkoviny (sušeného nebo zahuštěného mléka, nebo odebráním syrovátky). Ochucené kysané mléčné výrobky mohou obsahovat nejvýše 30 % hmotnostních ochucující složky. Kysané mléčné výrobky se skladují při teplotách 4 – 8 °C.
Kysané výrobky se vyznačují nízkým pH (3 – 4,5) a vysokou vodní aktivitou aw 0,98. Mikroorganizmy čistých kultur využívají základní složky mléka (mléčný tuk, laktózu i bílkoviny) jako hlavní živiny. Laktózu rozkládají homofermentativně za vzniku převážně kyseliny mléčné nebo heterofermentativně za vzniku dalších produktů – např. aceataldehydu, diacetylu, etanolu apod. Mohou také tvořit oxid uhličitý.
V čistých kulturách převládají laktobacily a laktokoky. Upravují pH výrobku a tím ho chrání před rozvojem hnilobných bakterií, rozkládají složité látky na jednodušší, lépe stravitelné a příznivě ovlivňují střevní mikroflóru. Některé se dovedou ve střevech implantovat.
Mléko pro výrobu zakysaných výrobků nesmí obsahovat žádné látky, které omezují nebo zastavují růst čistých kultur. Používané čisté kultury musí být aktivní. Do vysoce tepelně ošetřeného mléka, se po úpravě teploty na teplotu kultivační, přidá čistá kultura a nechá se množit. Aktivitou kultury se mění vlastnosti mléka – kyselost, konzistence, aroma, …
Kultivace mikroorganizmů probíhá ve zracích tancích nebo přímo v obalech (klasický jogurt).
+
Obr. 19. Jogurtová kultura na LS mediu
Po prokysání se výrobek balí a uchovává v chladu. Ke kontaminaci může dojít z nekvalitního zákysu čisté kultury, z nečistého zařízení a zejména při balení. Pro prodloužení trvanlivosti je vhodné aseptické balení a sterilní obal. Pro zajištění kvality výrobků se doporučuje používání „Ochranných kultur“, které brání zejména rozvoji kvasinek a plísní (Candida, Saccharomyces cerevisiae, Kluyveromyces fragilis), které se dostávají do výrobku ze vzduchu při výrobě nebo při balení, nebo je zdrojem ovocná složka.
Výrobky mohou být doplněny o probiotické kmeny bakterií a také se přidávají látky podporující jejich růst – prebiotika (oligo a polysacharidy, peptidy, bílkoviny a lipidy).
Koliformní bakterie ve výrobku znamenají nedodržení technologie nebo zpravidla špatné čištění. Kontaminace sporami Bacillus cereus se projevuje tvorbou proteáz, které se projeví sladkým srážením, nesouvislou sraženinou a chuťovými změnami. Patogenní mikroorganizmy v zakysaných výrobcích nerostou.
+
Obr. 20. Koliformní bakterie na VČŽL.
Tabulka 3. Složení mikroflóry některých zakysaných výrobků
Druh výrobku | Použité mikroorganizmy | Mléčná mikroflóra výrobku v 1 g |
Kysané nebo zakysané mléčné výrobky (např. kysané mléko, smetanový zákys, zakysané podmáslí, zakysaná smetana, kysané mléčné nápoje) | monokultury nebo směsné kultury bakterií mléčného kysání zpravidla: Lactococcus lactis subsp. lactis Lactococcus lactis subsp. cremoris Lactococcus lactis subsp. lactis biovar diacetylactis Leuconostoc mesenteroides subsp. cremoris, Leuconostoc mesenteroides subsp. dextranicum | 106 |
Acidofilní mléko | Lactobacillus acidophilus a další mezofilní, příp. termofilní kultury bakterií mléčného kysání | 106 Lactobacillus acidophilus |
Jogurt, jogurtové mléko | symbiotická směs Streptococcus thermophilus a Lactobacillus delbrueckii subsp. bulgaricus | 107 |
Kefír | zákys připravený z kefírových zrn nebo kefírové kultury, jehož mikroflóra se skládá z kvasinek zkvašujících i nezkvašujících laktózu a mezofilních a termofilních bakterií mléčného kysání rostoucí ve vzájemném společenství (např. Kluyveromyces marxianus, Sacharomyces unisporus, Sacharomyces cerevisiae, Sacharomyces exignus, Leuconostoc, Lactococcus a Aerobacter) | 107 |
Kefírové mléko | zákys skládající se z kvasinkových kultur (např. Kluyveromyces, Torulopsis nebo Candida valida) a mezofilních a termofilních kultur bakterií mléčného kysání rostoucí ve vzájemné symbióze | bakterie mléčného kysání 106 a kvasinky 102 |
Kysaný mléčný výrobek s bifidokulturou | Bifidobacterium sp. v kombinaci s mezofilními a termofilními bakteriemi mléčného kysání | 106 bifidobakterie |
2.7.1
Vady zakysaných výrobků
Uvolňování syrovátky – nízká sušina, překysání zralého jogurtu, pohyb během zrání a chlazení, nesprávný poměr laktobacilů a streptokoků.
Nízká kyselost, netypická chuť a vůně – slabá, přestárlá kultura, jednostranný vývoj streptokoků, kontaminace kultury, malá dávka kultury, krátká doba zrání, mléko s obsahem inhibičních látek.
Hořká chuť – nevhodná surovina, nedostatečné prokysání, kultura kontaminovaná proteolytickými mikroorganizmy (bakterie, kvasinky, Geotrichum candidum), výrobek skladovaný při vyšších teplotách.
Sladké srážení, netypická chuť – Bacillus cereus.
Táhlovitý jogurt – kultura dlouho skladovaná při nižší teplotě.
Výskyt bublinek a kanálků – kontaminace plynotvornými mikroorganizmy.
Povlak na povrchu – kontaminace kvasinkami a plísněmi.
Silně kvasničná příchuť – nežádoucí kontaminace kvasinkami.
Nečistá chuť – koliformní bakterie, Acetobacter, kvasinky.
Špatná aktivita kultur – napadení bakteriofágy
+

Obr. 21. Mikrobitest pro stanovení redukujících mikroorganizmů
+
Obr. 22. Geotrichum candidum